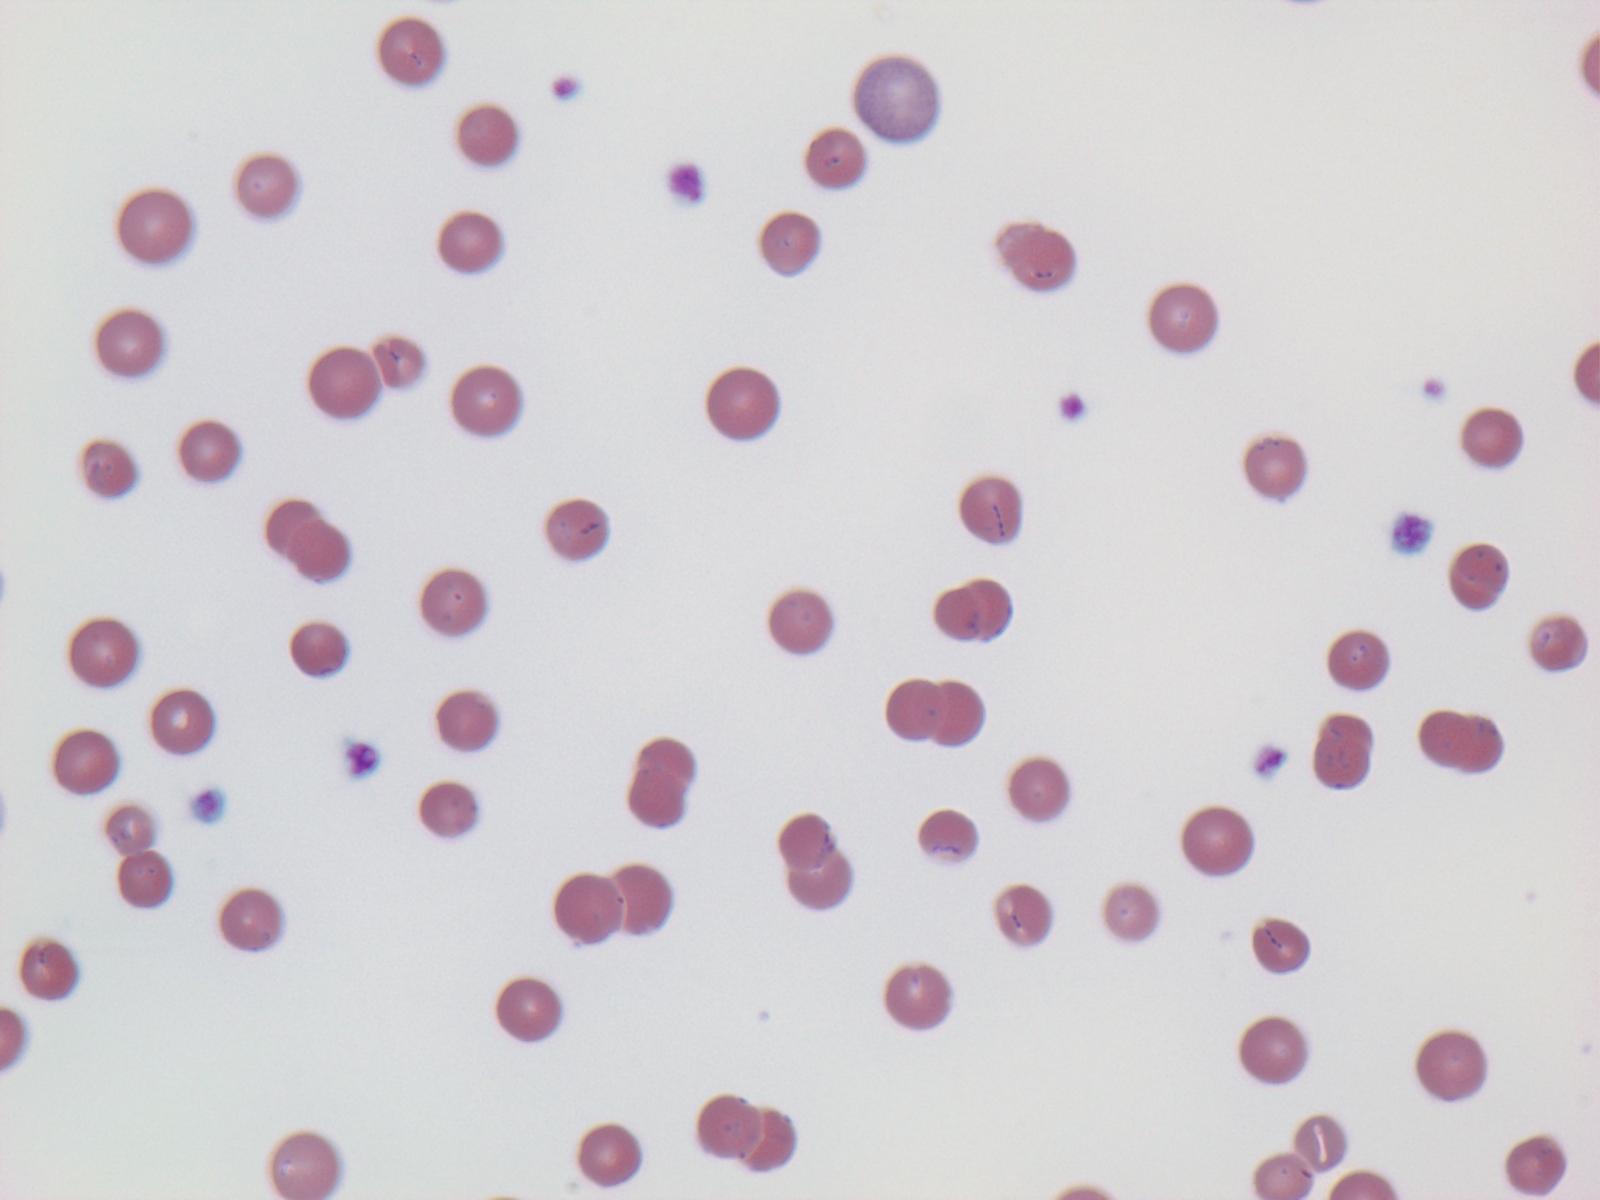

Mycoplasma (haemo)felis
Mycoplasma (haemo)felis - příznaky, přenos, inkubace a léčba
Bakterie, které způsobují záněty spojivek a urogenitální potíže, s Ureaplasmou se podílí na vzniku struvitů, je jedním z možných původců pyometry u koček, které nikdy nebyly nakryté. Pro člověka není riziková.
Příznaky: přivírání víček, slzení (vodnaté až hlenovité), záněty spojivek, zvýšené překrvení spojivky, otok, záněty urogenitálního aparátu a poruchy reprodukce, potraty, úmrtí koťat, deformované plody
Přenos: přímý kontakt: aerosol, výměšek horních cest dýchacích, oční výtoky, sekrety pohlavního ústrojí, trus
Inkubace: 3 - 10 dnů
Léčba: antibiotická,! bez kortikoidů
Neléčená mykoplasmóza přejde za 2-6 týdnů, ale má sklon k chronicitě.
Postihnuté zvíře musí být v karanténě
